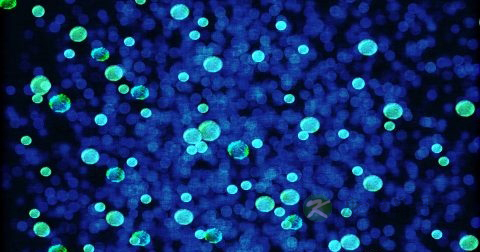
淋病病毒能杀死吗 淋病病毒能杀死吗

- 您好!欢迎来到康源名医金桥网

1、淋病病毒能杀死吗
淋病病原体对外界理化条件的抵抗力差,最怕干燥,在干燥环境中1-2小时即可死亡。在高温或低温条件下都易致死。对各种化学消毒剂的抵抗力也很弱。
2、超级淋病病毒的基本简介
据悉,“超级淋病病毒”的代号为H041,2011年首次发现于日本,美国和挪威等地也相继出现感染者。美国地区首例感染“超级淋病病毒”的患者是一位夏威夷的年轻女性,发现于2011年5月。目前美国疾病控制和预防中心已提请国会出资5000万美元针对该病毒寻找新的抗生素。
根据某卫生部官员介绍,这种病毒一旦传染起来,其后果可能比艾滋病还要糟糕。它们的侵略性相当强,能在短时间内感染更多的人。“某医生说:”感染者可能会在短短几天内出现脓毒性休克症状,甚至死亡。
3、淋病的早期症状
可侵犯眼睛、咽部、直肠和盆腔等处以及血行播散性感染引起关节炎、肝周炎、败血症、心内膜炎或脑膜炎等。潜伏期为1~14天,常为2~5天。表现为急性尿道炎症状,尿道口红肿、发痒及轻微刺痛,继而有稀薄黏液流出,引起排尿不适。约2天后,分泌物变得黏稠,尿道口溢脓,脓液呈深黄色或黄绿色,红肿发展到整个阴茎龟头及部分尿道,出现尿频、尿急、尿痛、排尿困难、行动不便、夜间阴茎常有痛性勃起。可有腹股沟淋巴结肿大,红肿疼痛,亦可化脓。有50%~70%的患者伴有淋球菌侵犯后尿道,表现为尿意窘迫、尿频、急性尿潴留。全身症状一般较轻,少数可有发热达38℃左右,全身不适,食欲缺乏等。
慢性淋病:症状持续2个月以上。因为治疗不彻底,淋球菌可隐伏于尿道体、尿道旁腺、尿道隐窝使病程转为慢性。
1、母婴传播
母婴传播是淋病传播的又一条途径。孕妇患淋病后能造成羊膜腔内感染,引起早产、胎儿感染等。胎儿经阴道分娩时又很容易被宫颈分泌物感染,引起新生儿淋菌性眼炎。这同样是淋病的传播途径中比较常见的一种。
2、性生活
淋病是一种传染性很强的性病,淋病双球菌只寄生在人体内,通过性生活传播是它的主要传播途径,成年人的淋病几乎都是通过性行为感染的。这是常见的淋病的传播途径。由于人类缺乏对淋病双球菌的先天免疫力,因此普遍易感;而患者病愈后获得的免疫力也很低,故还有可能被再次感染。
3、间接接触
间接接触感染也是常见的淋病的传播途径,如接触被患者分泌物污染的毛巾、浴盆、马桶坐便器,使用消毒不合格的医疗器械造成的医源性感染。虽然通过接触能引起淋病感染的途径很多,但被感染者仍为极少数。性生活传播才是淋病的主要传播途径。
1、基本简介
超级淋病病毒发现于13年5月的日本岛,自发现以来被命名为“H041”,由于其强悍的侵略性以及超强的感染性,并且其发病迅猛,短短几天的时间感染者就可能恶化到休克甚至死亡,因此H041自问世以来就为人们所忌惮。艾滋病毒大家应该都比较熟悉了,其危害性、对人体免疫系统个破坏能力,以及超强的感染性总是令人闻之色变,而超级淋病病毒作为淋病病毒的最新变种,也许与艾滋相比更胜一筹,这就意味着,H041相对于艾滋来说更加能给人带来威胁。当然这只是初步的推测。
2、强抗药性
病毒、细菌会根据周围的环境而自动调节变异方向,使得自身更好生存,而可怕的是其良好的变异结果可以传给新的变异体,也就是说在我们使用药物对引起疾病的细菌或者病毒进行抑制和消灭的时候,未被彻底消除的残余就会进一步进化变异,从而产生抗药性。
 豫公网安备 41110202000246号互联网药品信息服务资格证书:(豫)-经营性-2022-0039增值电信业务经营许可证:豫B2-20221313医疗器械经营备案编号:豫郑食药监械经营备20212188号
豫公网安备 41110202000246号互联网药品信息服务资格证书:(豫)-经营性-2022-0039增值电信业务经营许可证:豫B2-20221313医疗器械经营备案编号:豫郑食药监械经营备20212188号




